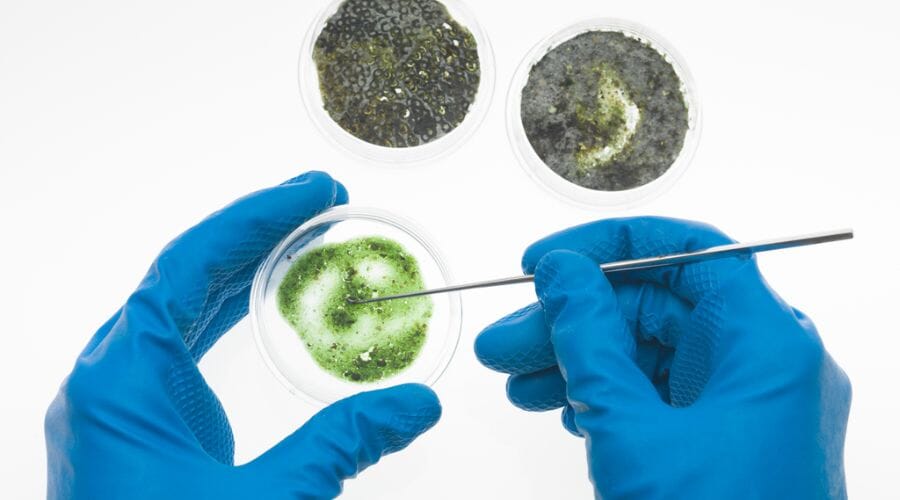
After results of mold inspection project completed for a property in Avery, TX

Trusted by 500+ Customers Across the Texas
Mold Inspection Services Avery, TX
- 24/7 Emergency Response — We're Always Ready
- IICRC Certified & Licensed Professionals
- Direct Insurance Billing — No Hassle Claims
- Advanced Equipment & Proven Techniques
- 100% Satisfaction Guaranteed
Texas Damage Restoration Pros is your trusted provider for mold inspection services in Avery, TX, addressing your mold concerns reliably. We boast over 165 reviews, inviting you to contact us now for help with our fast and effective solutions.
- Expert team with extensive experience.
- Same-day or next-day service available.
- Emergency assistance for urgent situations.
How We Can Help On Mold Inspection Services In Avery
If you’re worried about mold in your home, our mold inspection services in Avery can provide essential assessments for your safety. Our experienced team works diligently to identify and mitigate mold issues, ensuring a healthy environment for you and your family.
- We thoroughly inspect your property to locate any potential mold growth.
- Expect responsive communication, keeping you informed throughout the process.
- Our work not only resolves the issue, but we also ensure your property remains clean.
- We are fully certified and licensed, standing behind our work with strong guarantees.
- Our support includes thorough documentation, guiding you through every step.
Don’t let mold compromise your health. Reach out to us today to schedule your inspection!
Trusted by Homeowners & Businesses
Real Stories From Our Clients
When people call us, they are often dealing with stress, damage, and uncertainty. These reviews reflect the kind of response, care, and results we work hard to deliver every day.
Restoration Work Backed by Real Experience
From emergency water removal to full property restoration, we focus on fast response, honest communication, and results that help people feel at home again.

What Causes This Problem
- High humidity levels can promote mold growth indoors.
- Water leaks can lead to moisture accumulation.
- Insufficient ventilation creates a breeding ground for mold.
- Flooding increases the risk of mold infestations significantly.
Avery’s humid climate makes it especially important to monitor for mold growth, as higher humidity can create conditions conducive to mold. It’s crucial to perform regular inspections and consider our mold testing services in Avery to ensure your home remains safe from mold hazards.
Why Choose Our Team
- We prioritize quick response times, ensuring your mold concerns are addressed immediately.
- Our skilled technicians deliver exceptional workmanship while maintaining a tidy work environment.
- We possess all required certifications and licenses, reinforcing our commitment to quality service.
- With over 165 positive reviews, our reputation speaks volumes about our service quality.
- We provide thorough documentation and updates, reducing any stress associated with mold issues.
Service Cost In Avery
Pricing for mold inspection services in Avery generally ranges from $300 to $1,000, depending on the complexity of the inspection.
Service Areas (Within ~30 Miles Of Avery)
Avery 75424, Bagwell 75412, Clarksville 75426, Deport 75435, Paris 75460, Red River County 75460, Roxton 75477, Tira 75488, Talco 75487, Hughes Springs 75656, Mount Pleasant 75455, Pittsburg 75686, Mount Vernon 75457, Commerce 75428, Sulphur Springs 75482, Quitman 75783, Paris 75461, Linden 75563, Mount Pleasant 75456, Winnsboro 75494.
Our Work Process
- Conduct an initial consultation and site assessment for mold inspection.
- Utilize advanced tools to detect and identify mold presence.
- Provide a detailed report of findings and recommendations for remediation.
- Monitor the situation and ensure complete mold removal.
- Perform final checks to prevent future mold growth.
Customer Review
The mold inspection service was thorough and professional, giving me peace of mind. I highly recommend Texas Damage Restoration Pros!
— Sarah W., Avery
Frequently Asked Questions
What Is Hidden Mold Detection and Why Is It Important?
Hidden mold can cause significant harm to your property and health, making detection crucial. Our services include hidden mold detection in Avery to identify hidden threats effectively.
How Long Does a Mold Inspection Take?
A typical mold inspection can take anywhere from one to several hours, depending on the size of your property.
What Should I Do If Mold Is Found?
If mold is detected, it is vital to take immediate action to remediate the problem and prevent further growth.
Can I Continue Living in My Home During Mold Inspection?
Yes, you can remain in your home during an inspection, although avoiding areas where mold is suspected is advised.
How Often Should I Schedule Inspections?
Regular inspections, at least once a year, are recommended, especially in humid climates.

Meet Bruno Ferreri
𝗕𝗿𝗶𝗲𝗳 𝗕𝗶𝗼: Bruno Ferreri is a licensed Damage Restoration Expert with over 20 years of hands-on experience in property recovery. As a seasoned professional, he has navigated thousands of restoration projects, helping homeowners and businesses reclaim their spaces after devastating losses. His deep industry knowledge and commitment to excellence make him a trusted authority in disaster mitigation.
𝗖𝗲𝗿𝘁𝗶𝗳𝗶𝗰𝗮𝘁𝗶𝗼𝗻𝘀: Bruno holds multiple prestigious IICRC certifications, including Water Damage Restoration (WRT), Applied Microbial Remediation (Mold), Applied Structural Drying (ASD), Odor Control, and Fire and Smoke Restoration.
𝗙𝗮𝘃𝗼𝗿𝗶𝘁𝗲 𝗣𝗮𝘀𝘁𝗶𝗺𝗲: When he isn’t on a job site, Bruno enjoys hiking local trails and restoring vintage furniture, applying the same precision to woodworking that he does to property repair.
𝗕𝗲𝘀𝘁 𝗣𝗮𝗿𝘁 𝗼𝗳 𝘁𝗵𝗲 𝗷𝗼𝗯: “The most rewarding moment is seeing the relief on a client’s face when they realize their home is safe and whole again.
